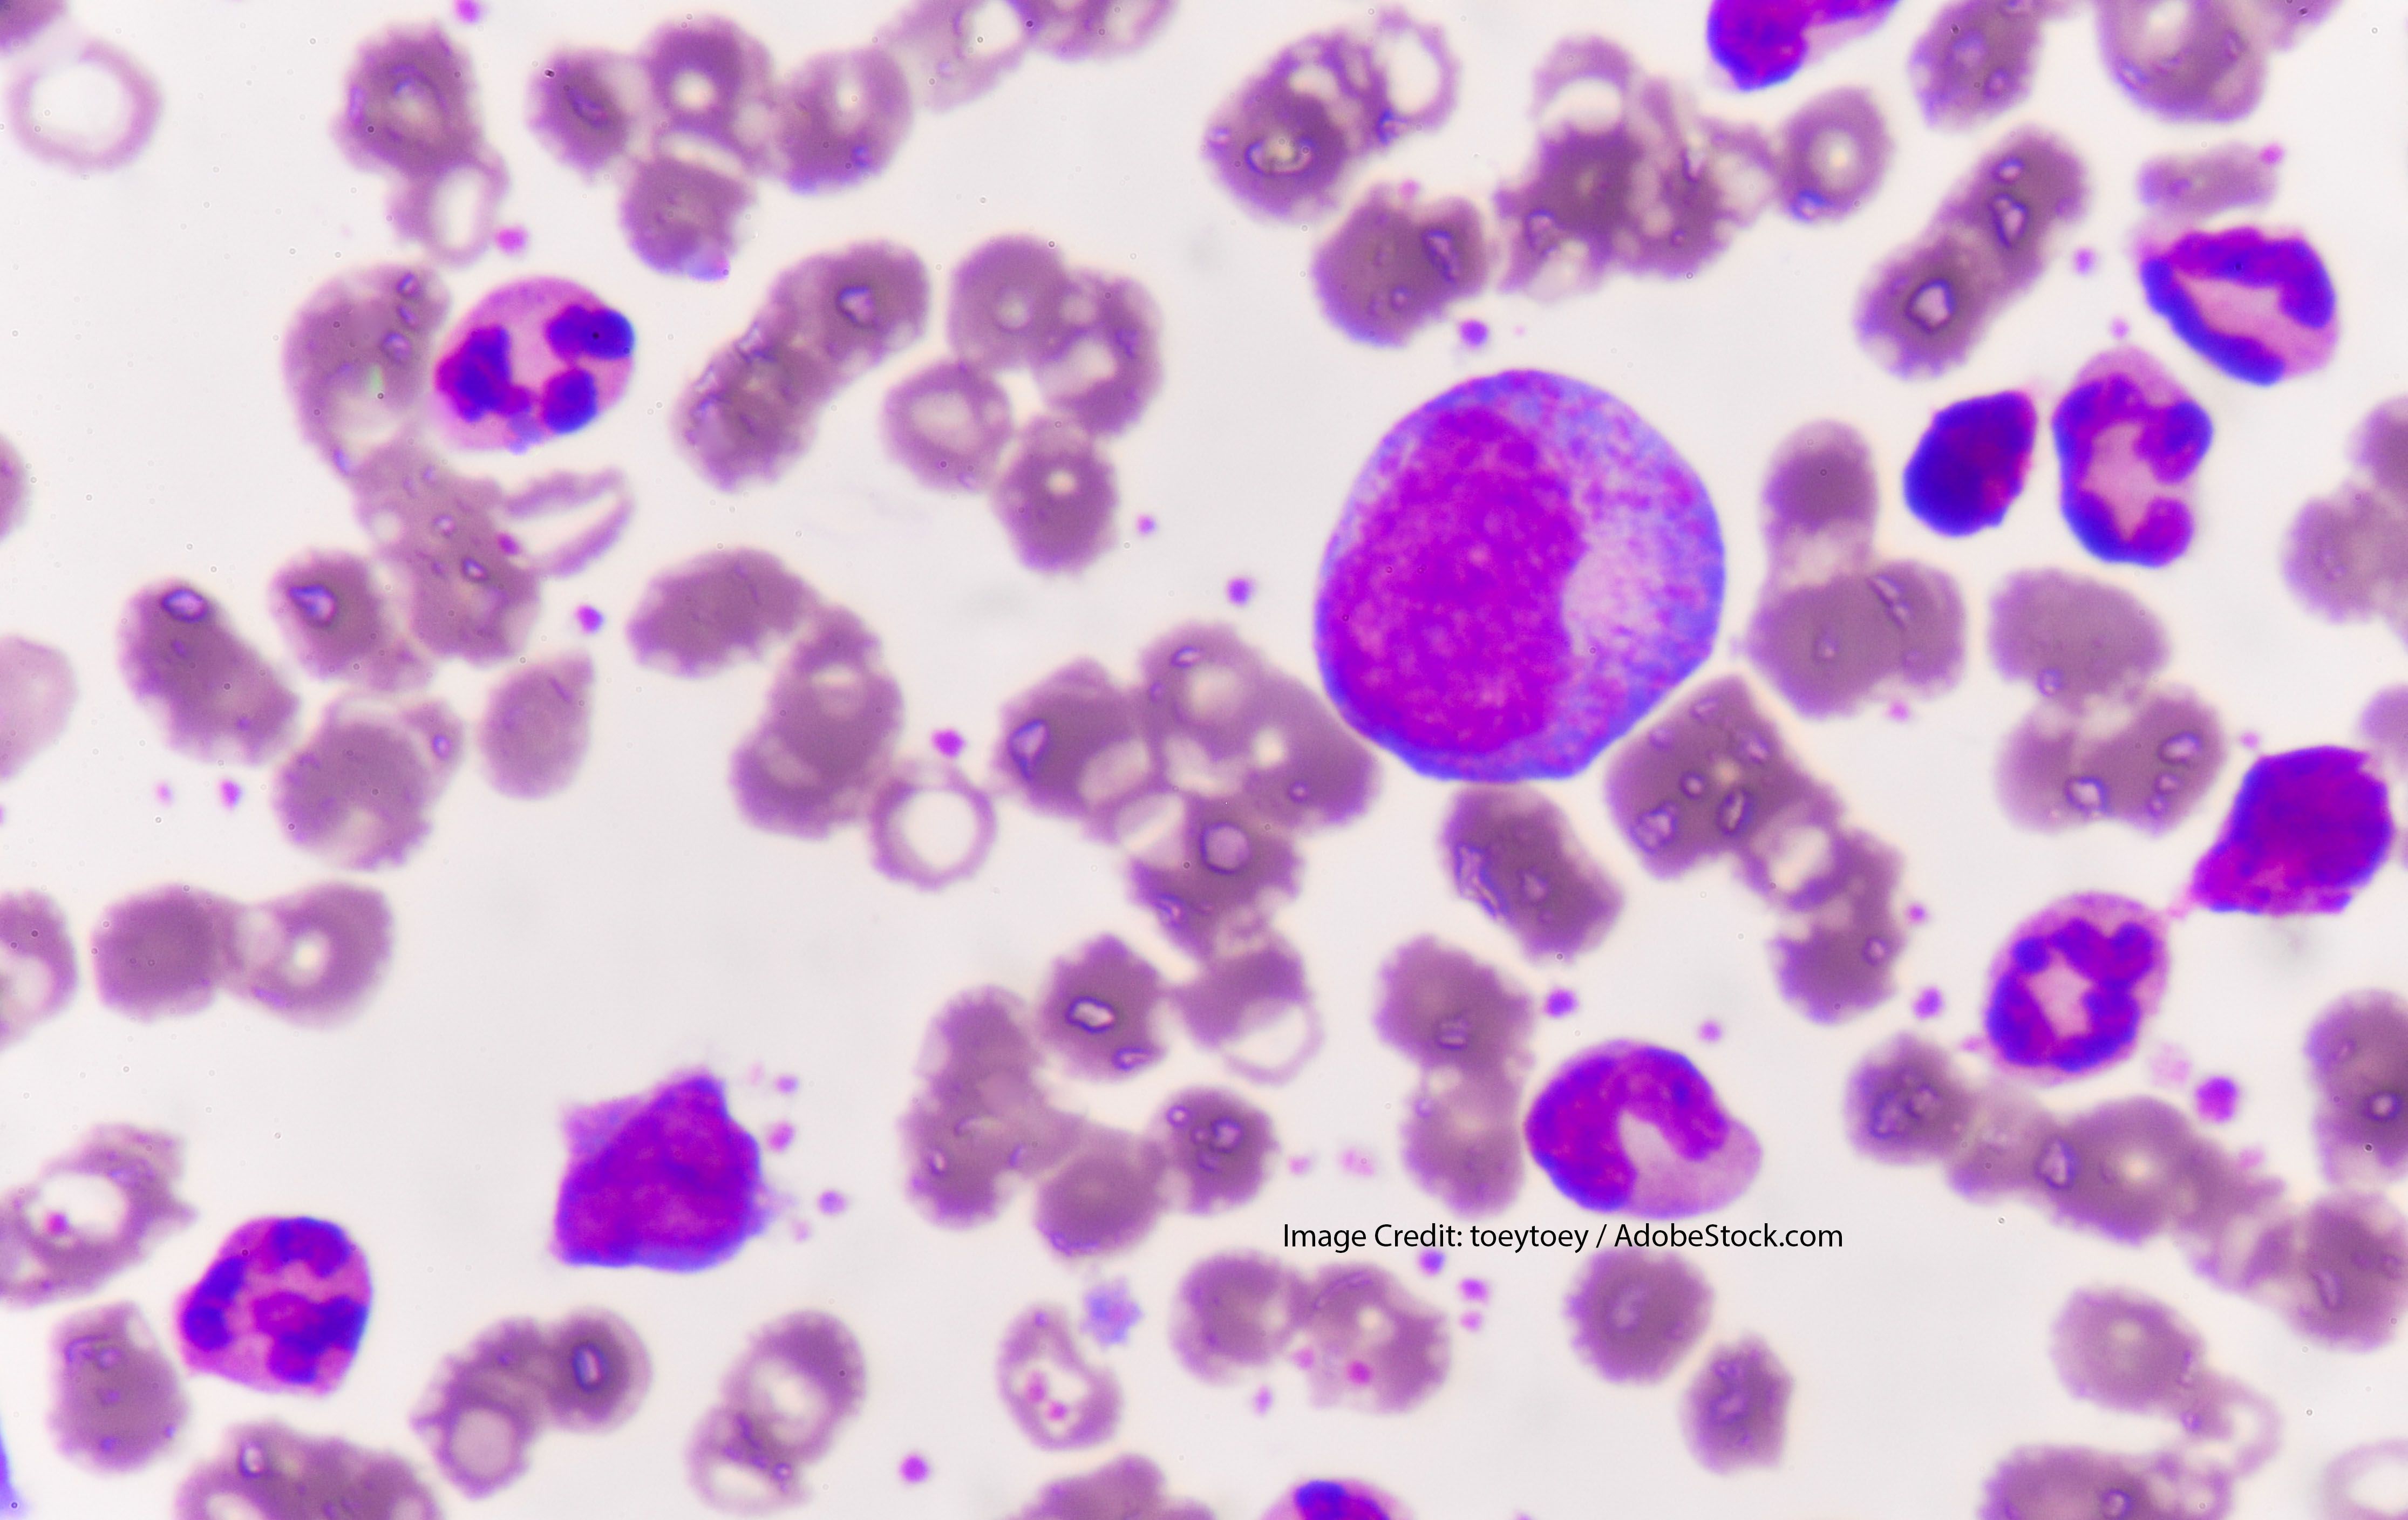

Clinicians now have a new treatment to offer elderly patients with newly diagnosed acute myeloid leukemia who have comorbidities that preclude the use of intensive chemotherapy.

Your AI-Trained Oncology Knowledge Connection!


Clinicians now have a new treatment to offer elderly patients with newly diagnosed acute myeloid leukemia who have comorbidities that preclude the use of intensive chemotherapy.

A study shows sequential monitoring of the WT1 mRNA is of value for the early detection of hematologic relapse in patients with AML in remission.

A patient’s minimal residual disease status may serve as a surrogate marker for outcome in clinical trials of chronic lymphocytic leukemia in patients with comorbidities.

Azacitidine may delay or prevent relapse among patients with MRD-positive acute myeloid leukemia or myelodysplastic syndrome.

Testing patterns associated with the diagnosis and treatment of chronic lymphocytic leukemia have changed rapidly during the last decade.

The results of a follow-up analysis to the phase III MAVORIC study were presented at the ASH 2018 Annual Meeting & Exposition.

In the single-arm, multicenter, phase II part of the CAVALLI trial, the researchers analyzed the efficacy of 800-mg venetoclax plus R-CHOP in all first-line DLBCL patients.

Research presented at ASH 2018 examined whether checkpoint blockade therapy sensitizes patients with relapsed/refractory NHL to consequent treatment.

Researchers analyzed a new recurrent BCL2 mutation appearing in a cohort of patients with CLL-type progressions treated with venetoclax.

Leukemia cells show sensitivity to restriction of BCL2 and BTK with the combination of venetoclax and ibrutinib.

Allogeneic hematopoietic stem cell transplantation could improve outcomes of elderly patients with acute myeloid leukemia.

Researchers used high throughput drug screening on leukemic stem cells to determine drug resistance and sensitivity in acute myeloid leukemia patients.

Researchers discovered clinical and experimental evidence that calls into question the widely held notion that LSCs preferentially outlive chemotherapy.

The ground-breaking study, led by the Leukemia & Lymphoma Society, is evaluating several novel targeted therapies for acute myeloid leukemia.

A study looks at the occurrence of treatment-related cardiotoxicity and its impact on pediatric AML patients.

New research evaluated whether symptomatic indolent follicular lymphoma requires new long-term therapy after first-line rituximab without chemotherapy.

A study shows that lower doses of ibrutinib after a full-dose cycle may be enough for continued biological activity.

Long-term data from the phase III HELIOS trial indicates ibrutinib plus bendamustine and rituximab improve survival outcomes in CLL patients.

Dr. Ian Flinn spoke with Cancer Network about incorporating the newest approved therapies for the management of CLL.

The research, published in JAMA Oncology, evaluates survival outcomes of a second allogeneic hematopoietic cell transplant vs donor lymphocyte infusion.
A study in The Lancet Haematology suggests this combination could become first-line for elderly or unhealthy patients with newly diagnosed AML.

A study shows stress may affect certain cellular, cytokine, and chemokine markers in the body of patients with CLL.

A study shows treatment with ibrutinib is superior to chemoimmunotherapy for patients with chronic treatment-naive CLL.

CX-01, a low-anticoagulant heparin derivative, has demonstrated good rates of complete remission, rapid platelet recovery, and no serious adverse events.

Although the study found lurbinectedin isn't promising, the presence of a chromosomal 11q21-23 abnormality may open doors in treating the disease.